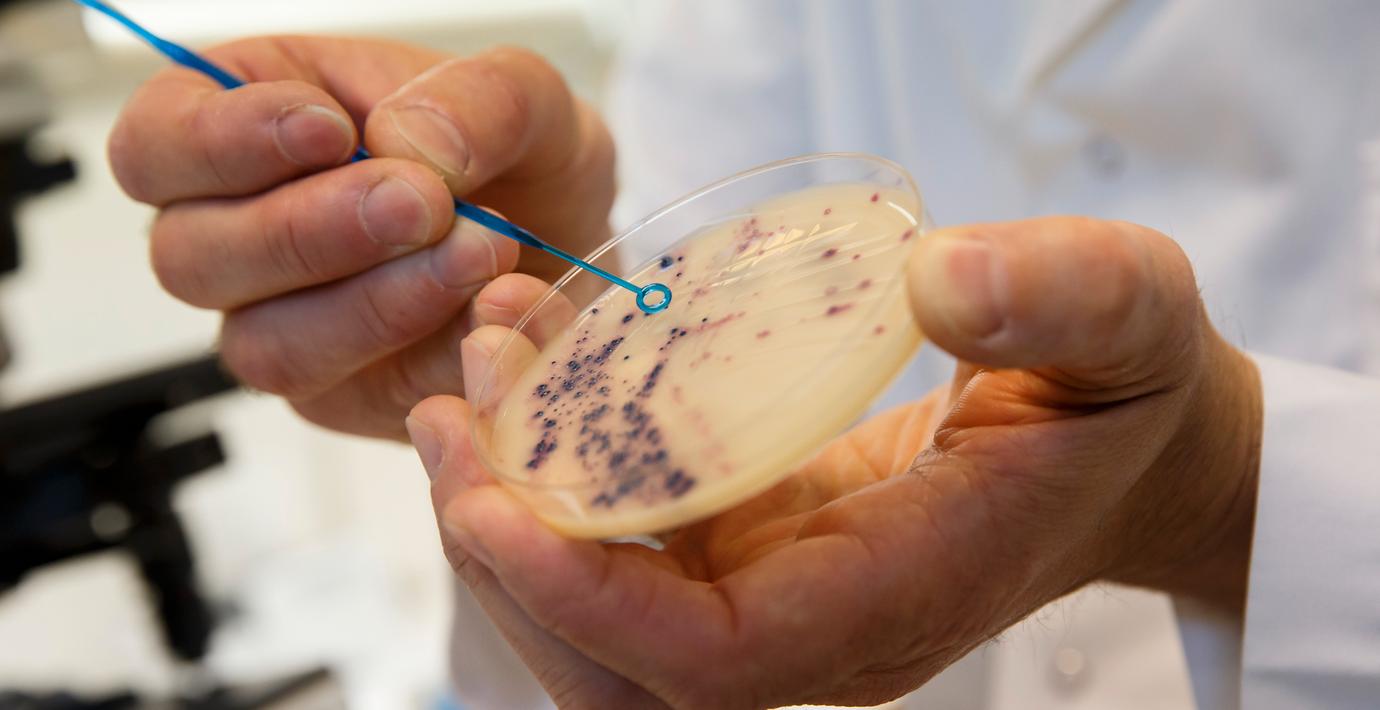

Studie: Nanoplast i kroppen kan blockera antibiotika
Små, små plastfragment – även kallade nanoplast – kan leta sig in i våra kroppar och göra oss sjuka. Och de kan också blockera effekten av antibiotika, visar en ny studie som letts från Umeå universitet, skriver TT.
I studien kunde forskarna se att plasten sög i sig antibiotikan, i det här fallet tetracyklin. Det gjorde att antibiotikan inte kunde döda bakterierna. Enligt forskarna finns en risk att antibiotikan följer med nanoplasten i blodomloppet och hamnar på fel ställen. Det finns också en risk för att bakterier blir antibiotikaresistenta. Det vore inte alls bra.
– Vad vi står inför nu är två stora problem som smälter ihop med varandra, säger Nikola Zlatkov Kolev, forskare vid Institutionen för molekylärbiologi vid Umeå universitet.
Omni är politiskt obundna och oberoende. Vi strävar efter att ge fler perspektiv på nyheterna. Har du frågor eller synpunkter kring vår rapportering? Kontakta redaktionen



